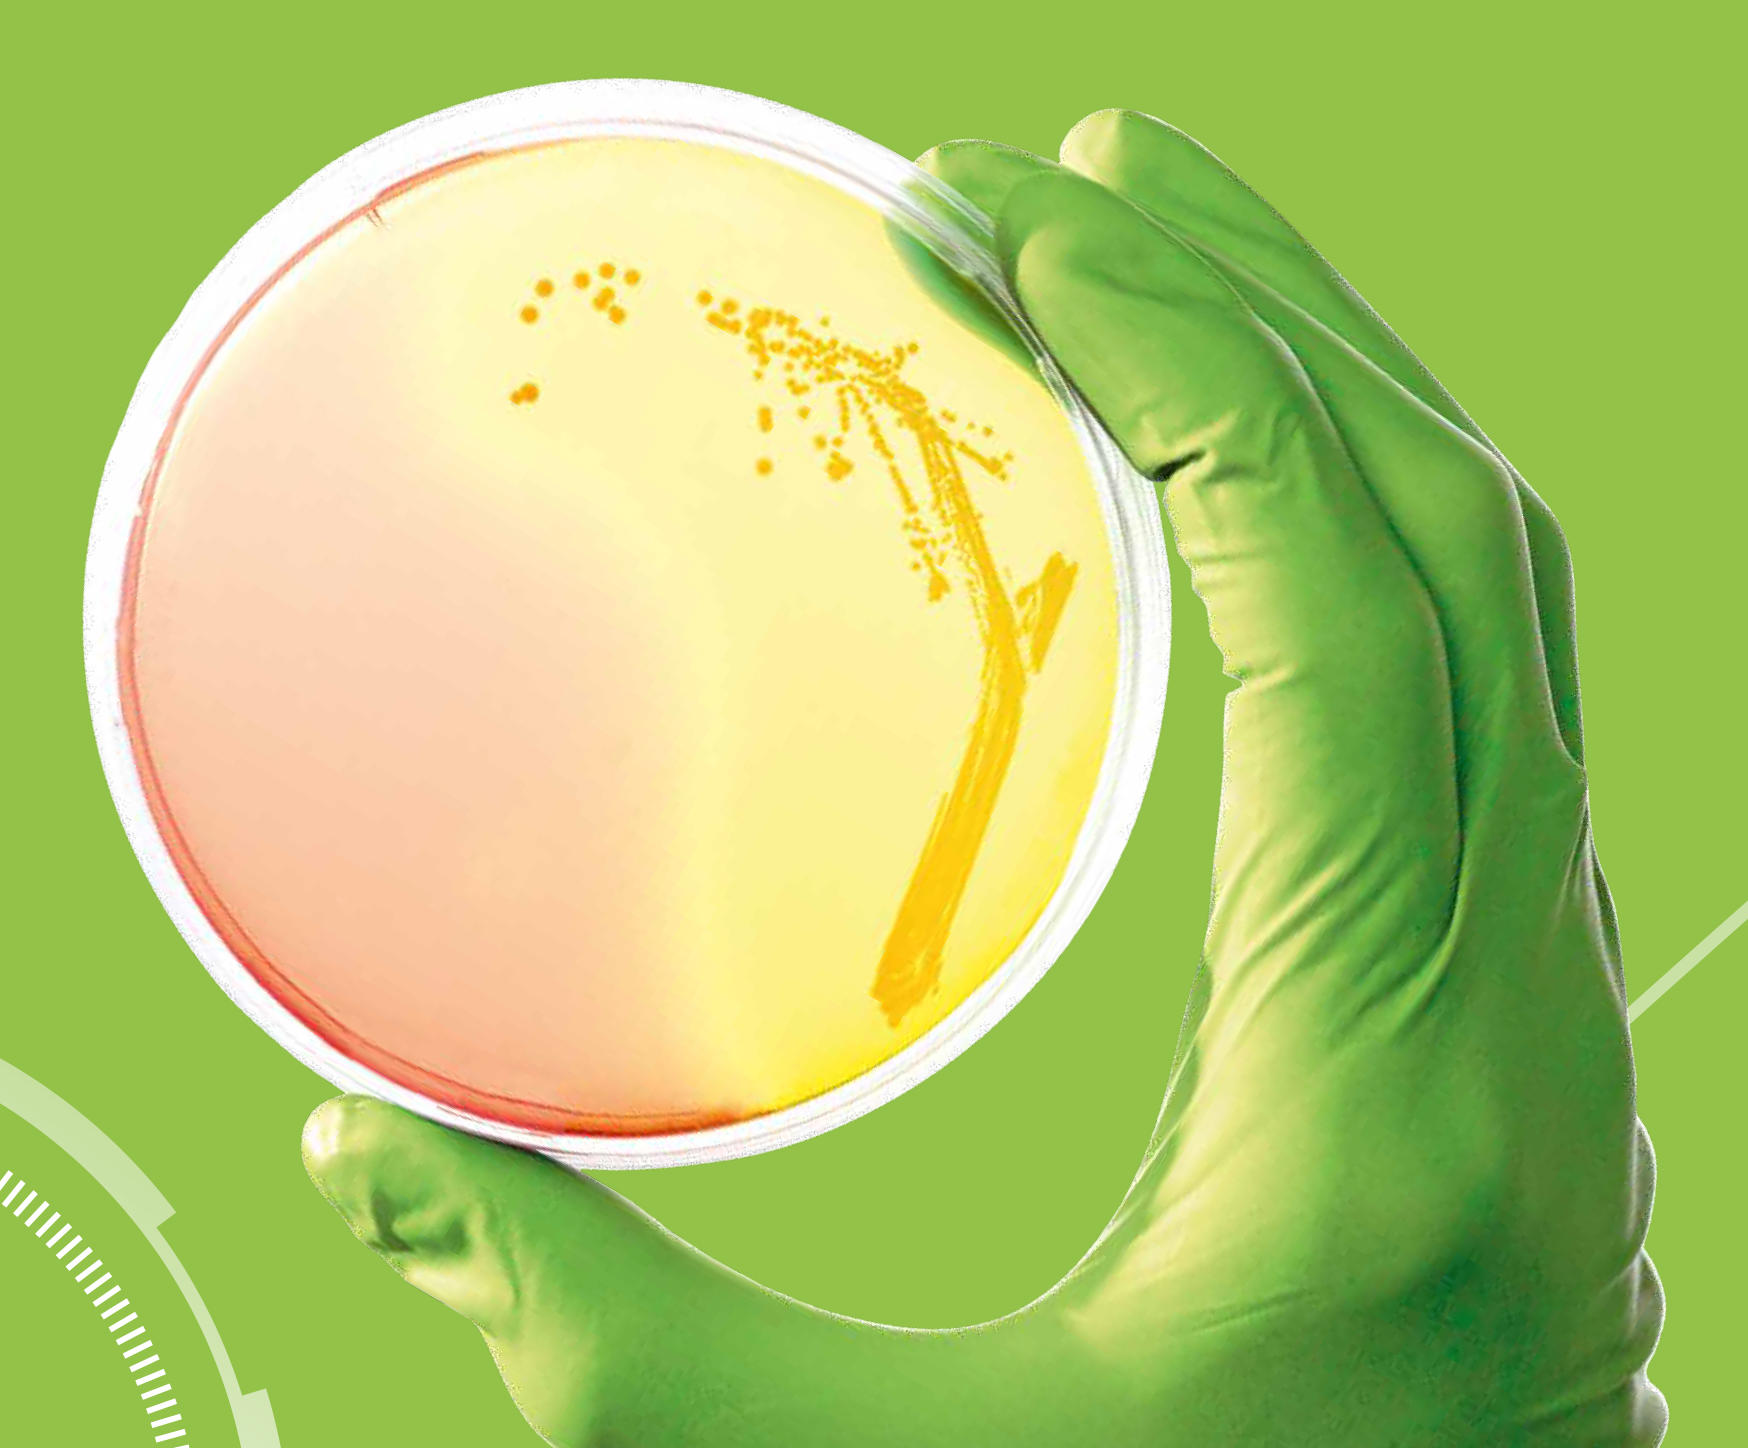
2.jpg

2026年4月23日,弗劳恩霍夫应用聚合物研究所(IAP)和德国NMI自然与医学科学研究所联合开发了一种正在申请专利的仿生组织替代品。该产品以3D打印技术为结构骨架,现已准备好进行工业转化。

这种在德国联邦研究、技术和航天部资助的PolyKARD项目下研发的材料,旨在解决生物医学工程领域最棘手的难题之一:复制天然组织的非线性力学行为。例如,心包等结构在轻载荷下会被拉伸,在压力下会迅速变硬,传统聚合物只能模拟这种响应的一端,而无法同时模拟另一端。新型多层结构设计则能同时实现这两种响应。
结构即解决方案
这种组织替代物由弗劳恩霍夫IAP波茨坦科学园的三层不同材料构成,每一层都发挥着特定功能:
●最底层:致密的聚氨酯丙烯酸酯聚合物薄膜。
●中间层:通过3D打印技术沉积的波浪状超结构——这是决定材料力学性能的关键层。当材料被拉伸时,波浪会拉长从而保持柔韧性;超过设定的应变阈值后,刚度会急剧增加,与天然心包组织的非线性应力-应变响应高度吻合。
●最外层:静电纺丝胶原蛋白,采用NMI开发的专有工艺生产,质量通过专门的酶分析和非侵入性光谱分析进行持续监控对人类皮肤成纤维细胞和上皮细胞的研究证实,纤维网络的三维形态能够有效支持细胞粘附和生长,细胞毒性测试表明没有对细胞产生不良影响。
NMI自然与医学科学研究所的Hannah Hartmann博士表示:"研究结果表明,技术材料和生物功能可以被专门设计并结合起来,制成仿生材料。这为生物混合植入物的开发开辟了新的可能性。因此,我们现在联合为这种组织替代物申请了专利。"

应用领域包括血管和皮肤移植
虽然心包是这项研发的主要参考组织,但这种材料概念并非特定于某种应用。同样的多层结构、可调超结构、聚合物基底和生物活性表面,可以应用于人工血管、支架移植物、硬脑膜替代物和人工皮肤。对于医疗器械公司而言,这代表的是一个可配置的平台,而非单一的植入解决方案。弗劳恩霍夫IAP的Wolf-Dietrich Meier博士解释道:"我们的研发成果已进入可转化为具体应用的阶段。下一步是与工业伙伴合作,开发具体产品并将它推向市场。"
3D打印仿生组织的新思路
多年来,在3D打印材料中复制软组织力学特性一直是研究热点。大多数方法都单独关注生物相容性或几何形状的定制,但匹配天然组织的非线性力学特性更具挑战性。德克萨斯农工大学生物医学工程系的研究发现,生物打印中使用的传统水凝胶缺乏足够的结构稳定性和组织特异性功能。明尼苏达大学的研究人员则证明,通过在体素尺度上控制丝材的几何形状,调整打印线的高度和间距,可以调节刚度比以匹配真实人体组织,从而在不改变基材的情况下实现与皮肤相当的各向异性。
弗劳恩霍夫IAP和NMI的研究方法正是基于此:该团队将刚化响应嵌入到打印的波状超结构中,而非聚合物本身,从而有效地将力学行为与材料选择解耦,使得设计逻辑无需从头开始重新设计即可应用于不同类型的组织和应用领域。
来源:南极熊





0 留言